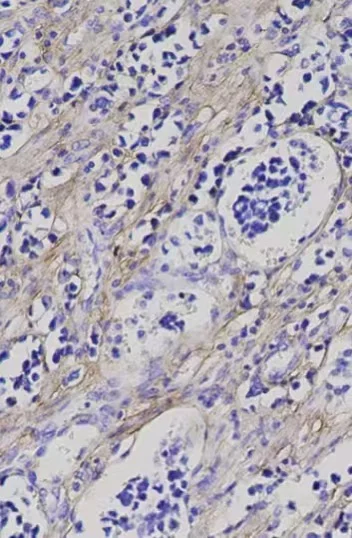
免疫组化染色步骤

样本固定:
从动物或人体取得所需的组织样本
将组织样本放入固定液中,常用的固定液有4%多聚甲醛溶液。一般室温下固定18-24小时
包埋
通过将组织样本嵌入到固体介质中,可以制作出适合在显微镜下观察的薄切片
脱水:在组织样本固定后,需要将其中的水分去除,以便于包埋介质能够充分渗透
透明:脱水后,使用透明剂去除酒精和其他溶剂,使组织样本变得透明
浸蜡:将透明后的组织样本放入温箱中,用石蜡浸泡3次,每次50分钟,以确保石蜡的均匀渗透。
包埋:将浸蜡后的组织样本放入模具中,倒入熔化的石蜡,然后让石蜡冷却凝固
切片
将包埋好的组织块固定在切片机的样本夹上,调整切片机的切片厚度,通常为4-5微米
将切片放在载玻片上,60℃烤片2小时
脱蜡水化
切片首先被置于二甲苯中浸泡,以溶解和去除切片上的石蜡。通常用二甲苯浸泡3次,每次5分钟
抗原修复
通过修复过程暴露被固定时隐藏的抗原表位,提高抗体的结合效率
洗涤:用PBS或TBS等缓冲液洗涤切片,浸泡2次,每次5分钟
封闭
封闭组织切片上非特异性结合位点,防止抗体与这些位点结合,从而减少背景信号
洗涤:封闭结束后,用PBS或TBS等缓冲液洗涤切片,以去除未结合的封闭液和可能存在的杂质
一抗孵育
根据实验目的选择特异性高、亲和力强的一抗
涂覆一抗:将稀释好的一抗均匀涂覆在已封闭的组织切片上,确保抗体能够充分接触组织切片上的抗原。
孵育:将稀释好的一抗均匀滴加在已封闭的组织切片上,放入湿盒中,室温(或37℃)孵育1小时,使一抗与抗原充分结合。
二抗孵育:
滴加与一抗种属匹配的二抗,确保二抗能够充分接触一抗。
孵育:将二抗均匀滴加在组织切片上,放入湿盒中,室温下孵育一定时间(如30分钟),使二抗与一抗充分结合。
洗涤:用PBS或TBS等缓冲液洗涤切片,以去除未结合的二抗和可能存在的杂质
显色
使用适当的显色剂(如DAB)使抗原-抗体复合物显色
复染
使用苏木素等染料对细胞核进行复染,以便在显微镜下更好地观察组织结构
脱水:将复染后的切片通过梯度酒精脱水,以去除水分
透明:使用二甲苯等透明剂使切片变得透明
封片:在切片上滴加适量的中性树胶,然后盖上盖玻片,封片固定
观察:将封好的切片放在显微镜下观察,记录实验结果。#医学生 #医生评职称 #动物实验外包 #细胞实验 #医学生#医生
从动物或人体取得所需的组织样本
将组织样本放入固定液中,常用的固定液有4%多聚甲醛溶液。一般室温下固定18-24小时
包埋
通过将组织样本嵌入到固体介质中,可以制作出适合在显微镜下观察的薄切片
脱水:在组织样本固定后,需要将其中的水分去除,以便于包埋介质能够充分渗透
透明:脱水后,使用透明剂去除酒精和其他溶剂,使组织样本变得透明
浸蜡:将透明后的组织样本放入温箱中,用石蜡浸泡3次,每次50分钟,以确保石蜡的均匀渗透。
包埋:将浸蜡后的组织样本放入模具中,倒入熔化的石蜡,然后让石蜡冷却凝固
切片
将包埋好的组织块固定在切片机的样本夹上,调整切片机的切片厚度,通常为4-5微米
将切片放在载玻片上,60℃烤片2小时
脱蜡水化
切片首先被置于二甲苯中浸泡,以溶解和去除切片上的石蜡。通常用二甲苯浸泡3次,每次5分钟
抗原修复
通过修复过程暴露被固定时隐藏的抗原表位,提高抗体的结合效率
洗涤:用PBS或TBS等缓冲液洗涤切片,浸泡2次,每次5分钟
封闭
封闭组织切片上非特异性结合位点,防止抗体与这些位点结合,从而减少背景信号
洗涤:封闭结束后,用PBS或TBS等缓冲液洗涤切片,以去除未结合的封闭液和可能存在的杂质
一抗孵育
根据实验目的选择特异性高、亲和力强的一抗
涂覆一抗:将稀释好的一抗均匀涂覆在已封闭的组织切片上,确保抗体能够充分接触组织切片上的抗原。
孵育:将稀释好的一抗均匀滴加在已封闭的组织切片上,放入湿盒中,室温(或37℃)孵育1小时,使一抗与抗原充分结合。
二抗孵育:
滴加与一抗种属匹配的二抗,确保二抗能够充分接触一抗。
孵育:将二抗均匀滴加在组织切片上,放入湿盒中,室温下孵育一定时间(如30分钟),使二抗与一抗充分结合。
洗涤:用PBS或TBS等缓冲液洗涤切片,以去除未结合的二抗和可能存在的杂质
显色
使用适当的显色剂(如DAB)使抗原-抗体复合物显色
复染
使用苏木素等染料对细胞核进行复染,以便在显微镜下更好地观察组织结构
脱水:将复染后的切片通过梯度酒精脱水,以去除水分
透明:使用二甲苯等透明剂使切片变得透明
封片:在切片上滴加适量的中性树胶,然后盖上盖玻片,封片固定
观察:将封好的切片放在显微镜下观察,记录实验结果。#医学生 #医生评职称 #动物实验外包 #细胞实验 #医学生#医生


